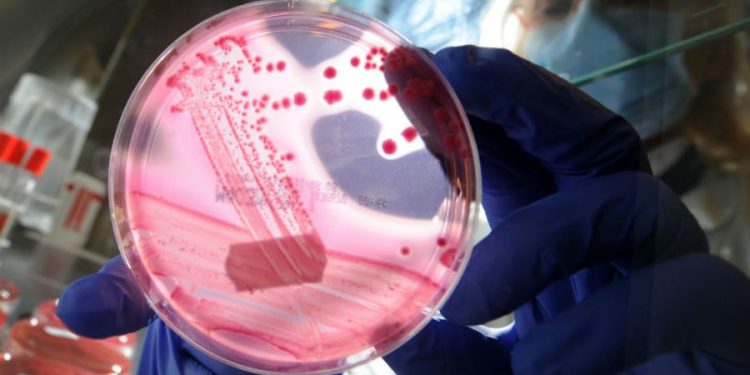
CDC investigating ‘fast-moving’ E. coli outbreak that has sickened dozens

Federal authorities are investigating a “fast-moving” E. coli breakout that was identified in Ohio and Michigan, with nearly 30 people infected by the bacteria from an unknown source.
The Centers for Disease Control and Prevention (CDC) has so far identified 29 people who have become ill due to E. coli infections. Nine of those have been hospitalized due to their illnesses, while no deaths have been reported. The first infection occurred late in July.
The ages of those infected range from 6 to 91.
The CDC said it is utilizing the PulseNet system in its investigation. PulseNet compares the “DNA fingerprints” of bacteria from affected patients to identify clusters of disease. Whole genome sequencing that has been performed indicates that the bacteria collected so far from affected patients are closely related.
The true number of people who are affected is likely higher, the CDC acknowledged, and there may be more cases in other states.
“Michigan and Ohio have both reported large increases in the number of E. coli infections in their states. Some of these illnesses have not yet been reported to the PulseNet system, but investigators are working quickly to add them to PulseNet to determine if they may be part of this outbreak,” the CDC said.
Symptoms of E. coli infections include diarrhea, a fever higher than 102 degrees Fahrenheit, vomiting to the point of being unable to keep down liquids and signs of dehydration. The CDC has asked that people who are experiencing symptoms keep a record of what they ate in the week before they became sick in order to help identify the possible source of the infection.
Symptoms usually occur within three to four days after someone has swallowed the E. coli bacteria, and most people will recover from their infections in about a week.
Some steps that can help prevent infections include washing your hands, utensils and cooking surfaces; separating raw meat, poultry and seafood from other foods that won’t be cooked with them; using a thermometer to ensure that a high enough temperature is reached to kill pathogens; and refrigerating perishable foods.
The Michigan Department of Health and Human Services (MDHHS) said this week that it has received reports of at least 98 cases of E. coli infections this month, nearly 80 more than what was reported in August last year. While the laboratory investigation is still in its early phases, the department said some cases have been linked to each other.
“While reports of E. coli illness typically increase during the warmer summer months, this significant jump in cases is alarming,” MDHHS chief medical executive Natasha Bagdasarian said in a statement.